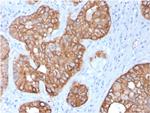
Cytokeratin 15 (Esophageal Squamous Cell Carcinoma Marker) Antibody in Immunohistochemistry (Paraffin) (IHC (P))

Search
NeoBiotechnologies
Cytokeratin 15 (Esophageal Squamous Cell Carcinoma Marker) Monoclonal Antibody (KRT15/2957)
{{$productOrderCtrl.translations['antibody.pdp.commerceCard.promotion.promotions']}}
{{$productOrderCtrl.translations['antibody.pdp.commerceCard.promotion.viewpromo']}}
{{$productOrderCtrl.translations['antibody.pdp.commerceCard.promotion.promocode']}}: {{promo.promoCode}} {{promo.promoTitle}} {{promo.promoDescription}}. {{$productOrderCtrl.translations['antibody.pdp.commerceCard.promotion.learnmore']}}
图: 1 / 9
Cytokeratin 15 (Esophageal Squamous Cell Carcinoma Marker) Antibody (3866-MSM7-P1ABX) in ICC/IF

产品信息
3866-MSM7-P1ABX
种属反应
宿主/亚型
分类
类型
克隆号
抗原
偶联物
形式
浓度
规格
纯化类型
保存液
内含物
保存条件
运输条件
靶标信息
Cytokeratin 15 is a member of the keratin gene family. The keratins are intermediate filament proteins responsible for the structural integrity of epithelial cells and are subdivided into cytokeratins and hair keratins. Most of the type I cytokeratins consist of acidic proteins which are arranged in pairs of heterotypic keratin chains and are clustered in a region on chromosome 17q21. 2.
仅用于科研。不用于诊断过程。未经明确授权不得转售。
篇参考文献 (0)
生物信息学
蛋白别名: C K1CO; CK-15; cytokeratin 15; Cytokeratin-15; K15; keratin 15, type I; Keratin, type I cytoskeletal 15; Keratin-15; keratin-15, basic; keratin-15, beta; KRT1; type I cytoskeletal 15; unnamed protein product
基因别名: CK15; K15; K1CO; KRT15; KRTB
UniProt ID: (Human) P19012
Entrez Gene ID: (Human) 3866




